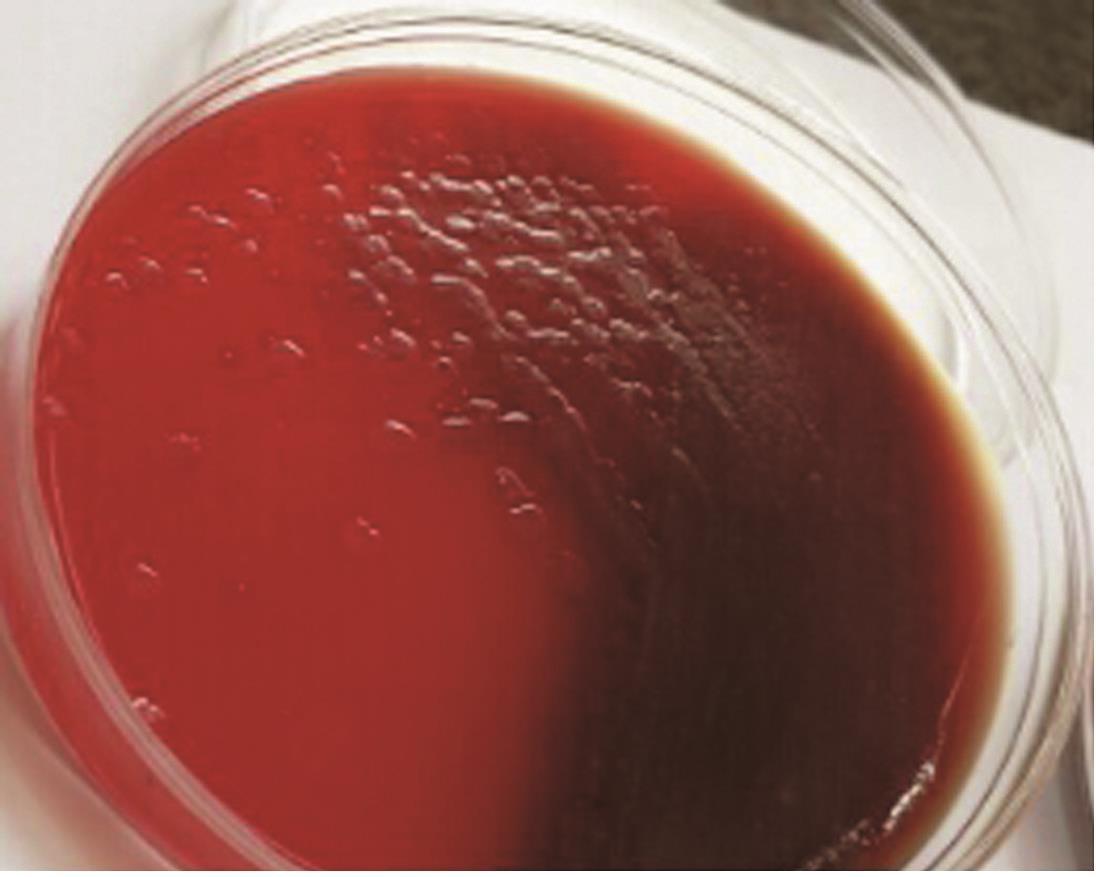
5.不可忽视的痰涂片

暗红色血痰图片

第1天为鲜红血液和血块,之后5天量减少,偶尔咳一下为痰中带点血(痰,血
图片尺寸615x631
有时候鲜红,有时候暗红,量大的时候可以变成血痰或者脓血痰,对于支
图片尺寸1080x607
血液营养不足,可引起肿瘤溃疡,坏死,病人咳嗽时,坏死组织会伴随痰咳
图片尺寸428x325
轻者出现心悸气短,活动后喘促,疲劳,乏力,咯血等左心功能不全症状.
图片尺寸627x432
痰中带血都有什么原因(痰中带血究竟是怎么回事)(2)
图片尺寸640x439
31周,有血块怎麼回事?
图片尺寸400x400
图片有点恶心有懂的人帮忙看一下
图片尺寸480x359
疼,声音都变得嘶哑了,上周杜先生清早咳嗽,咳出的痰里竟然见到了血,这
图片尺寸284x314
都具有危险性,比如鼻腔出血要注意鼻癌,咳血,痰中带血是咽喉癌的表现
图片尺寸341x191
吐痰带血是什么原因引起的
图片尺寸462x328
孕晚期血小板减少怎么办
图片尺寸1080x1439
红色痰液红色血丝痰液,多见于肺结核或支气管扩张,平时咽部有炎症,上
图片尺寸640x640
咳痰,为黄色粘痰伴痰中带血——淋巴细胞性间质性肺炎(lip)
图片尺寸556x552
痰培养中的念珠菌有致病性吗?_学术交流_检验视界_检验视界网
图片尺寸535x296
气机阻滞,血液运行不畅,久而化瘀;脾虚了呢,运化功能失调,湿聚成痰
图片尺寸1000x886
咳痰,为黄色粘痰伴痰中带血——淋巴细胞性间质性肺炎(lip)
图片尺寸556x552
5.不可忽视的痰涂片
图片尺寸1096x877
咳痰,为黄色粘痰伴痰中带血——淋巴细胞性间质性肺炎(lip)
图片尺寸556x552
咳痰,为黄色粘痰伴痰中带血——淋巴细胞性间质性肺炎(lip)
图片尺寸556x552
人一生中平均要吐25000品脱的痰,足以灌满两个游泳池.2.
图片尺寸580x426